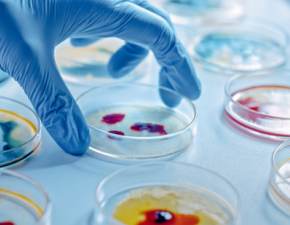

Co udało się odkryć?
Uczeni z Boston University School of Public Health w Massachusetts przeprowadzili analizy na 2126. kobietach z USA lub z Kanady oraz ich partnerach. Zrekrutowano pary, starające się o potomstwo. Zebrano wiedzę z zakresu socjologii, demografii i stylu życia współczesnego społeczeństwa. Przy tej okazji, podjęto się próby dowiedzenia, jaki wpływ mają szczepionki przeciwko wirusowi Covid-19 na płodność. Zweryfikowano pacjentów pod kątem szczepionek firm: Pfizer, Moderna i Johnson & Johnson.
Bezpłodność vs. szczepionki covidowe
Zdaniem naukowców, odsetek ciąż u kobiet, które przyjęły co najmniej jedną dawkę szczepionki, był niemal identyczny, jak wśród pań niezaszczepionych. Ta sama sprawa dotyczy również mężczyzn. Co ważne, dodatkowo przeanalizowano historię płodności, szczegóły dotyczące wykonywanych zawodów oraz miejsca zamieszkania par. Badania te również nie wykazały żadnych nieprawidłowości w kontekście związku szczepienia przeciwko Covid-19 z bezpłodnością.
Obniżona płodność u mężczyzn po Covid-19
To, że szczepionki nie mają nic do braku płodności, było informacją, która już od dłuższego czasu krążyła w wśród naukowców. Natomiast, najnowsze badania dowiodły, że istnieje związek pomiędzy niepłodnością a przebyciem zakażenia Covid-19 u mężczyzn. Wiadomo już, że infekcja koronawirusa przyczynia się do krótkotrwałej bezpłodności panów. Z analiz wynika, że mężczyźni, którzy otrzymali pozytywny test na obecność Covid-19 w okresie krótszym niż 60 dni od danego cyklu, mieli obniżoną płodność.
Wiele osób w wieku reprodukcyjnym przytacza obawy o płodność, jako powód nieszczepienia się. Nasze badanie wskazuje po raz pierwszy, że szczepienie przeciw Covid-19 któregokolwiek z partnerów nie ma wpływu na płodność par, próbujących zajść w ciążę poprzez stosunek płciowy
– wyjaśnia dr Amelia Wesselink, autorka pracy naukowej.
Źródło: PAP
Czytaj też: